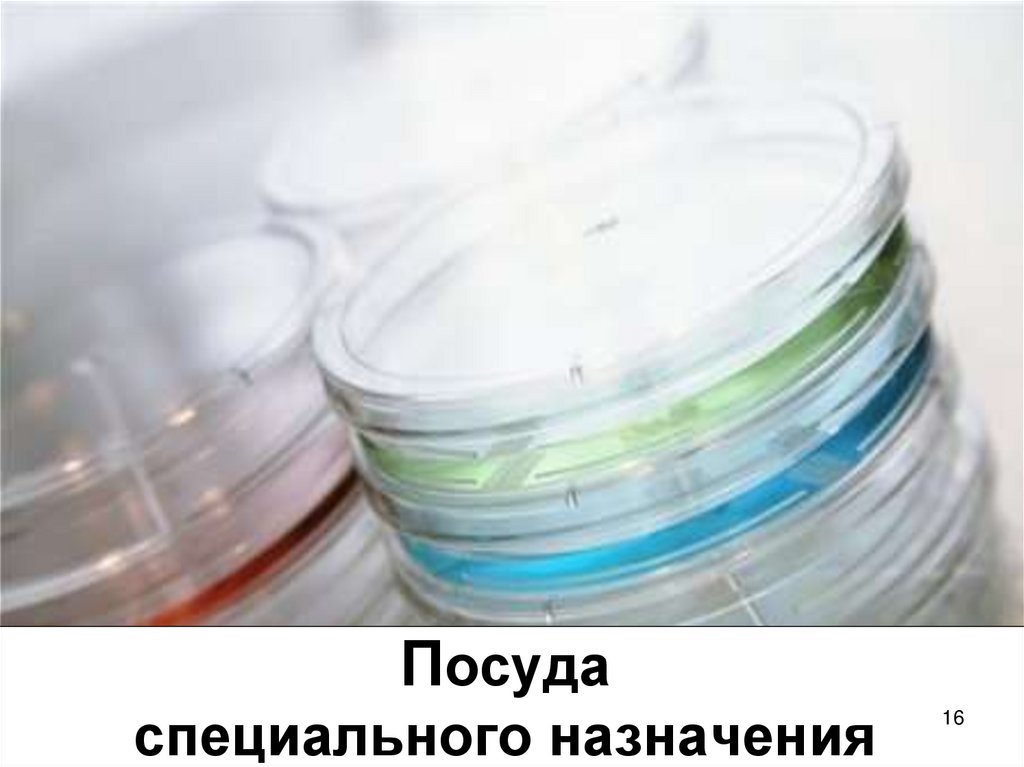
Посуда специального назначения

Similar presentations:
Химическая посуда и лабораторное оборудование
1.
Химическая посуда илабораторное оборудование
2. Классификация химической посуды
По материалупосуда из обычного стекла: бутыли для
хранения растворов, мензурки и др.;
посуда из специального химически и
термически стойкого стекла: пробирки,
стаканы, круглодонные колбы и др.;
посуда из кварца: колбы, пробирки,
стаканы, выпарительные чашки и др.;
посуда из фарфора: стаканы, тигли,
выпарительные чашки, ступки и др.
2
3. Классификация химической посуды
По назначениюпосуда общего назначения: посуда, которая
всегда должна быть в лаборатории и без
которой нельзя провести большинство работ
(пробирки, воронки, стаканы, конические
колбы, плоскодонные колбы, и др.);
посуда специального назначения: посуда,
которая употребляется для какой-либо цели
(дефлегматоры, холодильники, насадки,
круглодонные колбы и др.);
мерная посуда: посуда, предназначенная для
измерения объемов жидкостей (мерные
цилиндры, пипетки, бюретки, мерные колбы и
др. )
3
4.
Посуда общего назначения4
5. Посуда общего назначения Пробирки
Применяют для проведенияаналитических работ
Пробирки делятся на:
• обычные
• градуированные
• центрифужные
Обычные
5
Градуированные
Центрифужная
6. Посуда общего назначен Пробирки
Для хранения пробирок,находящихся в работе, служат
специальные штативы:
• деревянные
• пластмассовые
• металлические
Для мытья пробирок
используют ершики
6
7. Посуда общего назначения Пробирки
Нагревание пробирокДля нагревания
пробирки ее следует
зажать в держателе и
равномерно
прогревать в пламени
горелки
При нагревании открытый конец
пробирки должен быть обращен
в сторону от работающего
и от соседей по столу
7
8. Посуда общего назначения Химические стаканы
Представляют собой тонкостенные цилиндрыразличной емкости
Бывают :
• с носиком и без носика
• с делениями и без делений
Нагревать стаканы на открытом пламени нельзя!
8
9. Посуда общего назначения Конические колбы
Бывают:• различной емкости
• с делениями и без делений
• узкогорлые и широкогорлые
• со шлифом и без шлифа
Конические колбы
(Эрленмейера)
применяются при
аналитических работах
(титрование)
9
10. Конические колбы с отводом (Колба Бунзена)
1011.
• Круглодонная одногорлая11
12.
Грушевидная одногорлая12
13. Посуда общего назначения Плоскодонные колбы
Плоскодонные колбыбывают:
• различной емкости
• со шлифом
• без шлифа
13
14. Посуда общего назначения Воронки
Воронки бывают:• различных размеров
• обычные
• для фильтрования
(длинный конец,
угол 60 °)
Воронки используют для
переливания жидкостей, для
фильтрования, пересыпания
сыпучих веществ
14
15. Посуда общего назначения Промывалки
Промывалкииспользуют для
промывания осадков
дистиллированной
водой или какимлибо раствором, для
смывания осадков со
стенок сосудов
15
16. Посуда специального назначения
1617. Посуда специального назначения Делительные воронки
Делительныеворонки
применяют для
разделения
несмешивающихся
жидкостей
(например, воды и
масла)
17
18. Посуда специального назначения Кристаллизаторы
Кристаллизаторыприменяют при
кристаллизации и
перекристаллизации
веществ
18
19. Посуда специального назначения Холодильники
Холодильникиприменяют для охлаждения
и конденсации паров
Бывают:
• прямые (Либиха)
• обратные
(шариковые,змеевиковые
и др.)
19
20. Посуда специального назначения Круглодонные колбы
Круглодонные колбы бывают:разных размеров
со шлифом
без шлифа
одногорлые, двугорлые,
трехгорлые,
четырехгорлые
Для нагревания используют
специальные колбонагреватели
20
21. Посуда специального назначения Эксикаторы
Эксикаторыприменяют для
медленного высушивания,
остывания и сохранения
веществ, легко
поглощающих влагу из
воздуха
Эксикаторы бывают:
обыкновенные
вакуум-эксикаторы
21
22. Посуда специального назначения Бюксы
Бюкс - весовойстаканчик
Используется при
исследованиях,
связанных с
высушиванием
сыпучих
материалова,а
также как емкость
22
23.
Мерная посуда23
24. Мерная посуда Мерные цилиндры
Мерные цилиндры стеклянныетолстостенные сосуды
с нанесенными на
наружной стенке
делениями,
указывающими объем
в миллилитрах.
Бывают разной
емкости:
от 5-10 мл до 1 л
24
25. Мерная посуда Мерные колбы
Мерные колбыиспользуют для
приготовления точных
растворов при
проведении
аналитических работ
Бывают:
со шлифом
без шлифа
разных объемов
(25-1000 мл)
25
26. Мерная посуда Пипетки
Пипетки служат дляточного отмеривания
определенного объема
жидкости
Пипетки бывают:
простые (пипетки
Мора)
градуированные
Для наполнения пипеток используют
резиновые груши и насосы
26
27. Мерная посуда Бюретки
Бюреткиприменяют
для титрования,
измерения точных
объемов жидкости
Бывают
• с краном
• с зажимом
Мора
зажим Мора
27
28. Фарфоровая посуда
Преимущества:термостойкость
механическая
прочность
выдерживает резкие
перепады
температур
устойчива к горячим
кислотам, кроме
фосфорной и
фтороводородной
Недостатки:
• тяжелая
• непрозрачная
• неустойчива к
концентрированным растворам
щелочей
28
29. Фарфоровая посуда Ступки
Ступки применяютдля измельчения
твердых веществ
29
30. Фарфоровая посуда Выпарительные чашки, тигли
Выпарительные чашки широкоприменяют в лабораториях для
упаривания и выпаривания
растворов
Тигли – применяют для
прокаливания веществ
Фарфоровый треугольник используют при
нагревании тиглей
30
31. Фарфоровая посуда Воронки Бюхнера
Воронки Бюхнераотличаются от
обычных воронок
тем, что они имеют
перегородку с
отверстиями
Используют для
фильтрования под
вакуумом
31
32. Фарфоровая посуда Ложки, шпатели
Ложкииспользуют для
отбора веществ
Шпатели используют
для отбора веществ,
для снятия осадков с
фильтров
32
33. Металлическое оборудование
Тигельныещипцы
служат для
захватывания
тиглей
Ложки для отбора
веществ,
скальпель,
пинцет
33
34. Термометры
Термометрыприменяют для
измерения
температуры
Бывают:
• ртутные
• спиртовые
• без шлифа
• со шлифом
34
35. Металлическое оборудование
Штативы снабором
держателей
(лапок),
колец
и муфт
Служат для
закрепления на них
посуды и различных
приборов
35
36. Центрифуга
Устройство,служащее для
разделения сыпучих
тел или жидкостей
различного
удельного веса и
отделения
жидкостей от
твердых тел путем
использования
центробежной силы
36
37. Весы
Техническиевесы
Точность 2 цифры после
запятой
Аналитические
весы
Точность 4-5 цифр после
запятой (в зависимости
от модели весов)
37

chemistry
chemistry








